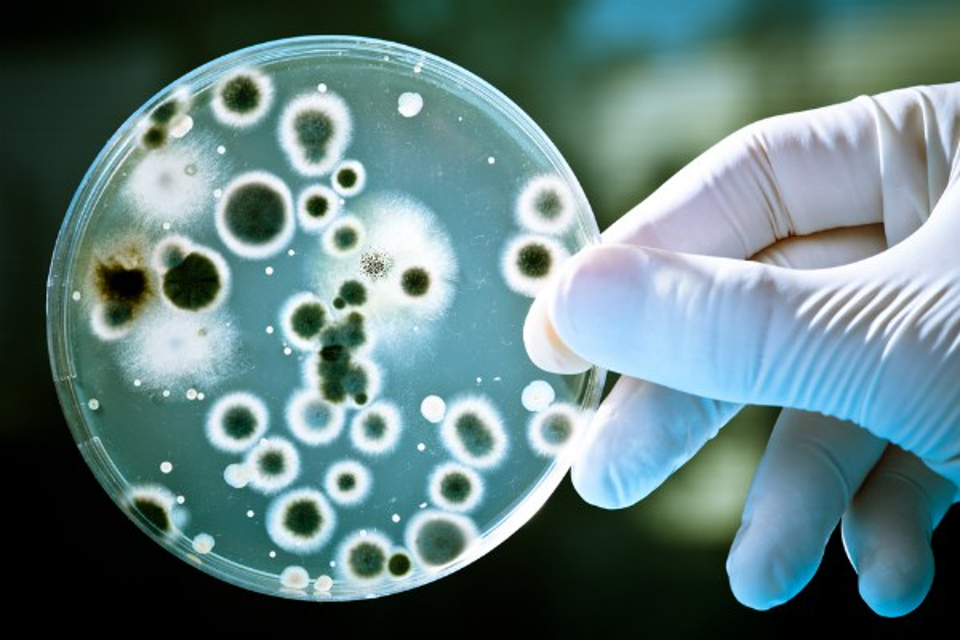
Бичил биетний талаарх сонирхолтой тоон илэрхийллүүд

Бидний эргэн тойронд микрометрээр хэмжигдэх өчүүхэн хэмжээтэйн улмаас бид энгийн нүдээр олж хардаггүй асар олон тооны бичил биетнүүд оршин байдаг. Бичил биетэнд археа, бактери, мөөгөнцөр, замаг, эгэл биетэн, вирус багтана. Тэдгээр нь экосистем, хүний өдөрт тутмын амьдралын салшгүй нэгэн хэсэг байж, асар их ач холбогдол, зарим талаар хор хөнөөл үзүүлж байдаг. Хэдийгээр эсийнх нь хэмжээ нүдэнд үл үзэгдэх өчүүхэн боловч бусад зүйлстэй харьцуулан гаргасан бичил биетний талаарх гайхшрам “том” тоонууд бий. Тэдгээрээс дор толилуулъя.
Бидний мэдэх орчлон ертөнцийн оддоос 100 сая дахин илүү тооны бактери (13х1028) далайд оршдог. Далайд секундэд 1х1023 вирусын халдвар гардаг ба энэ нь өдөр бүр нийт бактерийн
эсийн 20-40%-ийг устгадаг байна. Харин хуурай газар дээр гэвэл
нэг халбага хөрсөнд агуулагдах бичил биетний тоо (1х109) Африк тивийн хүн амын (2011
оны) тоотой
тэнцүү. Бүр гайхалтай нь шүдний өнгөрт бичил биетнүүд маш нягт бөөгнөрсөн байх
ба 1 граммд ойролцоогоор 1х1011 бактери байдаг нь өдийг хүртэл
дэлхий дээр амьдарч байсан бүх хүний тоотой ойролцоо юм. Насанд
хүрсэн хүний гэдсэнд ойролцоогоор 1 кг бактери байх ба хүн жил бүр өөрийн
биеийн жинтэй адил хэмжээний бактерийг ялгадастай хамт гадагшлуулдаг. Орчны
тааламжгүй нөхцөлд бичил биетнүүд спор үүсгэн урт хугацааг даван туулах
чадвартай. Жишээлбэл: Хув чулуун дотроос амьдрах чадвартай бактериуд ялгасан ба
тооцоолсноор тэд 34000-170000 жилийн настай ажээ.
Магадгүй Микробиологийн шинжлэх
ухаан дахь хамгийн аймшигтай тоонууд нь өвчин үүсгэгчидтэй холбоотой. Дэлхий
даяар жил бүр 16 сая хүн халдварт өвчнөөр нас бардаг ба нас баралтын ихэнхийг урьдчилан
сэргийлэх боломжтой байдаг. Дэлхий дээр 12 хүн тутмын нэг нь буюу 500 сая
хүн архаг вируст гепатиттай ба хламидын шинэ халдварын тоо жилд ойролцоогоор
50 сая гэсэн тооцоо бий. Одоогийн байдлаар хүнд өвчин үүсгэгч бичил биетний
1400 зүйл мэдэгдэж байгаа нь их мэт санагдаж болох ч дэлхий дээрх
нийт бичил биетний зүйлийн 1%-аас ч бага хэмжээ юм..jpg?w=1000)
.png?w=1000)
Ашигласан эх сурвалж: Microbiology by numbers. Nature
Reviews
Microbiology
(2011) 9: 628.
Бэлтгэсэн: Микробиологийн лабораторийн э.ш.дад.ажилтан Б.Бумцэнд
Хянасан: Лабораторийн эрхлэгч, доктор Ж.Энх-Амгалан